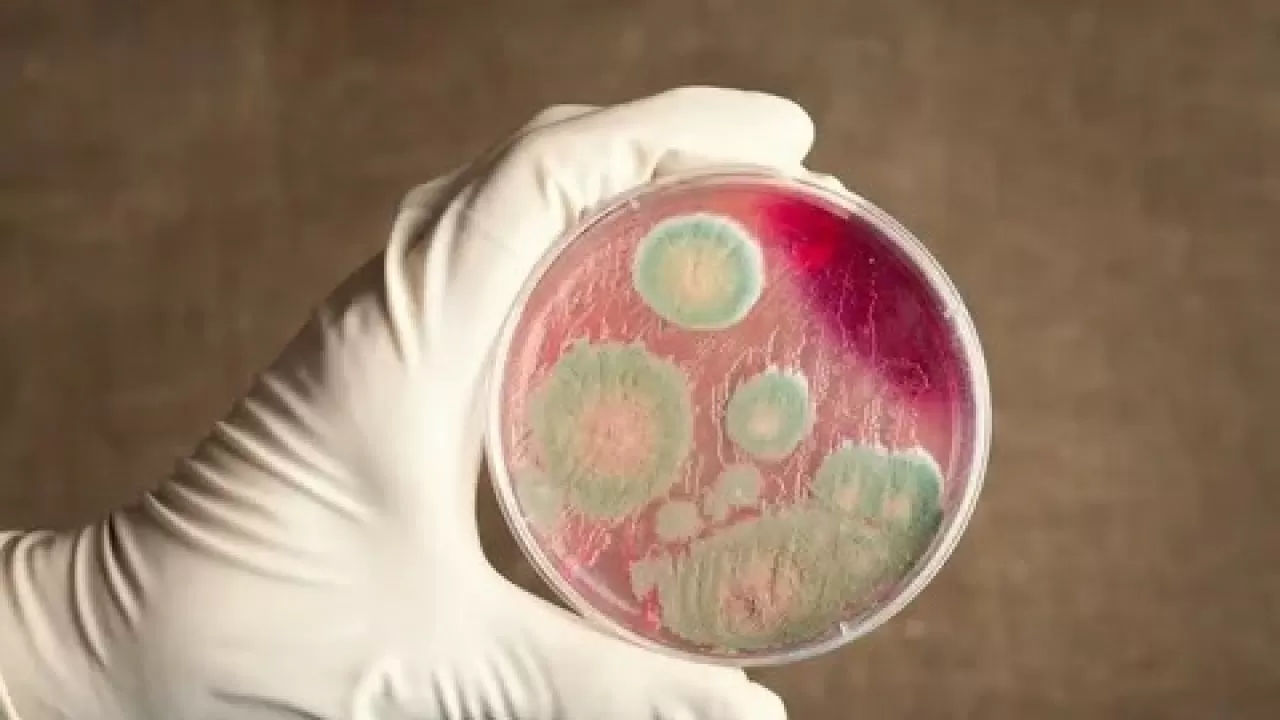
Угрожает ли сибирская язва жителям Алматинской области

В Илийском районе Алматинской области, в селе Байсерке, обнаружен старый скотомогильник сибирской язвы, который сегодня находится на частной территории, находящейся в ведении ТОО "Транспетролеум", сообщает inbusiness.kz со ссылкой на пресс-службу акимата Алматинской области.
Согласно архивам, здесь были захоронены крупный рогатый скот в 1958 году и две лошади в 1968 году.
По информации пресс-службы акимата, вокруг захоронения установлена санитарно-защитная зона радиусом 1000 метров. Эта зона частично захватывает жилые кварталы села Байсерке, а также прилегающие участки соседнего села Киши Байсерке Талгарского района.
Сообщается, что вопросы сноса домов или переселения жителей не рассматриваются, и в настоящее время для местного населения угрозы нет.
Для детального изучения ситуации и выработки мер распоряжением акима Илийского района была создана рабочая группа во главе с заместителем акима. В состав группы вошли представители ветеринарной инспекции, санитарно-эпидемиологического контроля, отдела земельных отношений, а также научные консультанты из Казахского научно-исследовательского ветеринарного института.
Рабочая группа уже провела два заседания и приступила к исследовательской работе совместно с учеными. Сейчас проводится анализ архивных документов для уточнения точного местоположения захоронения и корректировки санитарно-защитной зоны.
"Ожидается, что окончательное решение о судьбе захоронения и его санитарной зоне будет принято в течение ближайшего месяца на итоговом заседании группы. По результатам этих работ также будут внесены изменения в решение акима Илийского района о местах захоронений сибирской язвы", - проинформировали в пресс-службе акимата Алматинской области.
Читайте по теме:
Сибирская язва и рынок мяса: ждать ли казахстанцам роста цен